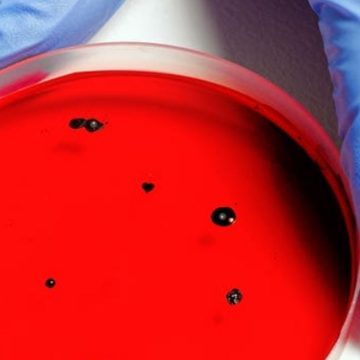
Covid Francia, nuova variante

Doc nelle tue mani 2, anticipazioni: la serie Tv di Rai 1 sta per tornare sugli schermi di milioni di italiani che stanno attendendo la seconda stagione con trepidazione, dopo il grande successo della prima. Doc nelle tue mani 2 anticipazioni Al centro ci sarà la storia con le difficoltà di Luca Argentero ma la...
Author: Domenico Iovane (Domenico Iovane)
Doc 2: quando esce, cast, novità, anticipazioni
Doc 2, la serie tv con protagonista Luca Argentero presto arriverà in prima serata. La prima stagione della serie tv targata Rai ha fatto un grande successo, soprattutto nel periodo pandemico.
Addio al marchio Buitoni dopo quasi 200 anni
Addio al marchio Buitoni: è storia e rischia di finire dopo quasi 200 anni di produzione. La multinazionale Nestlé, detentrice del logo, non è intenzionata a rinnovare la concessione. Addio al marchio Buitoni Il marchio Buitoni rischia seriamente la fine della sua storia. Il brand è nato nel 1827 a Sansepolcro (Arezzo), grazie allo spirito imprenditoriale di...
Covid Francia, nuova variante scoperta proveniente dal Camerun
Covid Francia, nuova variante scoperta a fine novembre a sud del paese. Proveniente probabilmente dal Camerun, è stata rilevata su circa 67 pazienti. Covid Francia, nuova variante scoperta A fine novembre nel Sud della Francia sono risultate positive a una variante sconosciuta del Covid-19. Gli esperti parlano già di una nuova variante da Coronavirus. Il paziente zero era...
Riaperture scuole a gennaio: è caos. Slittamento o conferma?
Riaperture scuole: a meno di una settimana dal 10 gennaio è caos sul rientro a scuola. Le vaccinazioni per i bambini e ragazzi sono appena iniziate e l’aumento dei contagi spaventa. Riaperture scuole a gennaio: è caos La data delle riaperture delle scuole si avvicina ma non c’è ancora chiarezza sulle misure da adottare. La...
Accredito pensione gennaio 2022 in banca: le date
Accredito pensione gennaio 2022: quali sono le date e da quando è possibile già riscuotere. A rispondere a questi dubbi ci pensa l’Inps direttamente pubblicando anche tutte le date del 2022. Accredito pensione gennaio 2022 Sono state pubblicate le date di riscossione della pensione per il mese di gennaio sia per quanto riguarda le poste...
Smartphone Blackberry: che cosa succede dal 4 gennaio 2022
Smartphone Blackberry: che cosa succede. Per i vecchi dispositivi si va verso un graduale spegnimento senza più aggiornamenti. Il sistema operativo non riceverà più supporto. Smartphone Blackberry: che cosa succede dal 4 gennaio 2022 Gli smartphone BlackBerry con i sistemi operativi BlackBerry 7,1 e 10 oltre a quello per tablet PlayBook OS 2.1 inizieranno dal 4 gennaio a non...